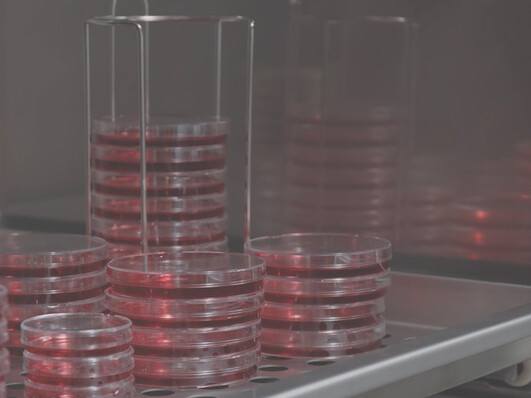

Veelzijdige toepassingen voor elke uitdaging
Onze markten
Bij Hettich Benelux bieden wij hoogwaardige laboratoriumapparatuur die geschikt is voor uiteenlopende toepassingen; van klinische diagnostiek en farmaceutisch onderzoek tot voedselveiligheid, plantkunde en life science. Onze betrouwbare en nauwkeurige producten zorgen voor optimale resultaten en meer efficiëntie in elk laboratorium.
Ontdek hoe onze oplossingen uw werkzaamheden in diverse sectoren kunnen ondersteunen. Bekijk ons assortiment of neem vandaag nog contact op met onze deskundig team.
Medisch
Hettich is een fabrikant (marktleider) van medische centrifuges en incubatoren, allemaal IVDR-gecertificeerd en al jarenlang vertrouwd in klinische diagnostiek en transfusiegeneeskunde. Onze producten staan bekend om hun betrouwbaarheid en innovatie en zijn gebouwd om uw laboratoriumactiviteiten jarenlang te ondersteunen.

Agro
Hettich Benelux biedt geavanceerde oplossingen voor plantwetenschappen en tuinbouw, waaronder plantengroeikamers en -kasten met LED-verlichting, klimaatregeling (temperatuur, vochtigheid en CO₂) en automatische bewateringssystemen met cloud-gebaseerde bewaking op afstand. Onze klimaatkamers kunnen op maat worden gemaakt en zowel binnen als buiten worden geïnstalleerd, afhankelijk van uw wensen.

Voeding
Hettich Benelux produceert het MoPlant systeem voor vetanalyse en droge stof (o.a. melk producten). Ons oliebad is speciaal ontworpen om de hittestabiliteit van mager melkpoeder te bepalen, terwijl ons fermentatiebad gebruikers in staat stelt om een verscheidenheid aan zuivelproducten te testen en te ontwikkelen door middel van nauwkeurige temperatuurgradiënten en pH-regeling.

Farmaceutisch
Hettich Benelux levert state-of-the-art apparatuur voor farmaceutisch onderzoek, waaronder stabiliteitskamers, incubatoren en centrifuges. Ze zijn allemaal ontworpen om te voldoen aan de hoogste normen voor omgevingscontrole, waardoor ze ideaal zijn voor onderzoek, ontwikkeling en experimentele toepassingen.

Life Science
Ons uitgebreide assortiment omvat centrifuges, incubatoren, bioveiligheidskasten, klimaatkamers en -kasten, koelsystemen (inclusief vriezers voor ultralage temperaturen). Hierdoor kunnen we uw laboratorium uitrusten met moderne, betrouwbare en hoogwaardige oplossingen voor elke biowetenschappelijke toepassing.